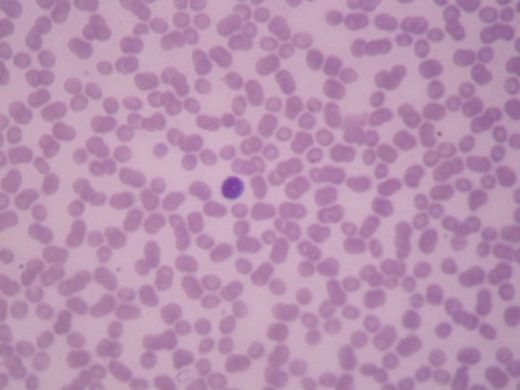
İdrarda Bakteri Belirtileri ve Tedavisi

İdrarda Bakteri Belirtileri ve Tedavisi
İdrarda bakteri varlığı, idrar yolu enfeksiyonlarının önemli bir belirtisidir. Belirtiler arasında yanma, sık idrara çıkma ve kötü kokulu idrar yer alabilir. Erken tanı ve tedavi, enfeksiyonun yayılmasını önlemek için kritik öneme sahiptir. Sağlıklı yaşam tarzı ve önleyici tedbirler, enfeksiyon riskini azaltmada etkilidir.
İdrarda bakteri varlığı, genellikle idrar yolu enfeksiyonlarının (İYE) bir belirtisi olarak kabul edilir. Bu durum, çeşitli semptomlarla kendini gösterebilir ve tedavi edilmediği takdirde ciddi sağlık sorunlarına yol açabilir. Bu yazıda, idrarda bakteri belirtileri, tanı yöntemleri, tedavi seçenekleri ve önleyici tedbirler detaylı bir şekilde ele alınacaktır. İdrarda Bakteri Belirtileri İdrarda bakteri varlığı genellikle aşağıdaki belirtilerle kendini gösterir:
Bu belirtiler, genellikle idrar yolu enfeksiyonlarının yanı sıra böbrek enfeksiyonları veya mesane iltihabı gibi durumlarla da ilişkilidir. Tanı Yöntemleri İdrarda bakteri varlığını tespit etmek için birkaç temel tanı yöntemi bulunmaktadır:
Tanı süreci, hastanın belirtilerine ve genel sağlık durumuna bağlı olarak değişiklik gösterebilir. Tedavi Seçenekleri İdrarda bakterilerin varlığı durumunda tedavi genellikle aşağıdaki şekillerde yapılır:
Tedavi süreci, hastanın genel sağlık durumu ve enfeksiyonun ciddiyetine bağlı olarak değişiklik gösterebilir. Önleyici Tedbirler İdrar yolu enfeksiyonlarının önlenmesi, sağlıklı bir yaşam tarzı ve bazı basit önlemlerle mümkündür:
Bu önlemler, idrar yolu enfeksiyonlarının riskini önemli ölçüde azaltabilir. Sonuç İdrarda bakteri varlığı, ciddiye alınması gereken bir durumdur ve belirtiler ortaya çıktığında mutlaka bir sağlık profesyoneline başvurulmalıdır. Erken tanı ve tedavi, enfeksiyonun yayılmasını önleyebilir ve komplikasyon riskini azaltabilir. Sağlıklı yaşam tarzı ve gerekli önlemler, idrar yolu enfeksiyonlarının önlenmesinde önemli bir rol oynamaktadır. Ekstra Bilgiler İdrar yolu enfeksiyonları, kadınlarda erkeklere göre daha yaygındır. Bunun sebebi, kadınların üretralarının erkeklere göre daha kısa olmasıdır. Ayrıca, idrar yolu enfeksiyonuna neden olan bakteriler genellikle bağırsak florasında bulunur ve tuvalet kullanımı, cinsel ilişki veya hijyen eksikliği gibi durumlarla vücuda girebilir. Tedavi sürecinde, hastaların antibiyotik tedavisini tamamlaması ve doktorun önerilerine uyması önemlidir. Ayrıca, bazı bireylerde tekrar eden idrar yolu enfeksiyonları görülebilir. Bu durumlarda, doktorlar ek önlemler ve tedavi yöntemleri önerebilir. |

İdrarımda bakterilerin olduğunu, test sonucunda öğrendim. Sık sık idrara çıkma isteğim var ve idrar yaparken yanma hissediyorum. Bu belirtilerle ilgili çocuklarımı da takip etmeli miyim? Ayrıca, özellikle böbrek taşından dolayı idrarda bakteri oluşumu ne kadar yaygın? Bu taşları düşürmek bakterilerin tekrar ortaya çıkmasını engeller mi? Son olarak, antibiyotik tedavisi yanında bitkisel çözümler denemek istiyorum. Kuşburnu çayı gerçekten etkili mi?
Merhaba Berkün Bey,
Öncelikle, yaşadığınız belirtiler çok rahatsız edici olabilir, bu nedenle sağlığınızı yakından takip etmeniz önemli.
Çocukları Takip Etmek: Eğer çocuklarınızda benzer belirtiler görürseniz, onları da bir doktora götürmek iyi bir fikir olabilir. Çocuklarda idrar yolu enfeksiyonları daha nadir ama ciddi olabilir, bu nedenle dikkatli olmakta fayda var.
Böbrek Taşı ve Bakteriler: Böbrek taşları, idrar yolunda tıkanıklığa neden olarak bakterilerin çoğalmasına zemin hazırlayabilir. Taşları düşürmek enfeksiyon riskini azaltabilir, ancak tamamen ortadan kaldırmaz. Bu nedenle, böbrek taşlarının nedenini ve tekrar oluşmaması için alınacak önlemleri doktorunuzla görüşmelisiniz.
Bitkisel Çözümler: Kuşburnu çayı C vitamini açısından zengin olup, bağışıklık sisteminizi güçlendirmeye yardımcı olabilir. Ancak, bitkisel çözümler tek başına yeterli olmayabilir. Antibiyotik tedavisine destek olarak kullanabilirsiniz, ama mutlaka doktorunuza danışarak hareket etmelisiniz.
Sağlıklı günler dilerim.